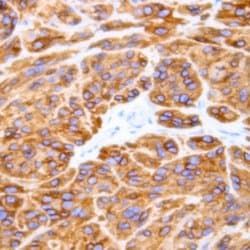
Img

S100 Polyclonal Antibody, Abbomax
Manufacturer: Abbomax Inc
Select a Size
| Pack Size | SKU | Availability | Price |
|---|---|---|---|
| Each of 1 | 50-220-3644-Each-of-1 | In Stock | ₹ 17,711.00 |
50-220-3644 - Each of 1
In Stock
Quantity
1
Base Price: ₹ 17,711.00
GST (18%): ₹ 3,187.98
Total Price: ₹ 20,898.98
Antigen
S100
Classification
Polyclonal
Conjugate
Unconjugated
Gene
S100A1
Gene Alias
AI266795; AI850290; Bpb; hypothetical protein LOC525716; NEF; Protein S100-A1; protein S100-B; S 100; S100; S100 alpha; S100 calcium binding protein A1; S100 calcium binding protein B; S100 calcium-binding protein A1; S100 calcium-binding protein B; S100 calcium-binding protein beta (neural); S100 calcium-binding protein, beta (neural); S-100 calcium-binding protein, beta chain; S-100 protein alpha chain; S-100 protein beta chain; S-100 protein subunit alpha; S-100 protein subunit beta; S100 protein, alpha polypeptide; S100 protein, beta polypeptide; S100 protein, beta polypeptide, neural; S100a; S100A1; S100alpha; S100-alpha; S100B; S100-B; S100beta; S100P
Immunogen
Recombinant protein encoding human S100 protein
Quantity
100 μg
Primary or Secondary
Primary
Target Species
Bovine, Human, Mouse, Rat
Product Type
Antibody
Isotype
IgG
Applications
Immunohistochemistry (Paraffin), Immunohistochemistry (PFA fixed), Western Blot
Concentration
0.5 mg/mL
Formulation
PBS with proprietary stabilizer and 0.01% sodium azide
Gene Accession No.
P02638, P02639, P04271, P04631, P23297, P35467, P50114, P56565
Host Species
Rabbit
Purification Method
Antigen affinity chromatography
Regulatory Status
RUO
Gene ID (Entrez)
20193, 20203, 25742, 295214, 525716, 528735, 6271, 6285
Content And Storage
Store at 4°C short term. For long term storage, store at -20°C, avoiding freeze/thaw cycles.
Form
Liquid
Description
- Positive control: Melanoma or Schwannoma Cellular location: Cytoplasmic
- S100 Polyclonal antibody specifically detects S100 in Bovine, Human, Mouse, Rat samples
- It is validated for Immunohistochemistry (Paraffin), Immunohistochemistry (PFA fixed), Western Blot